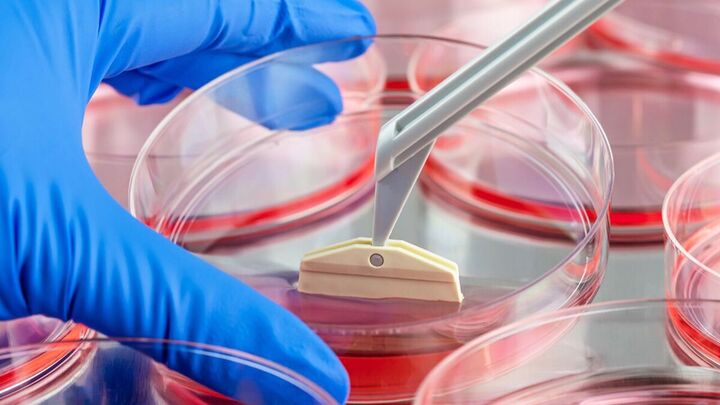
«داربستهای سهبعدی نانویی» راهحل درمان رایجترین علت نابینایی «داربستهای سهبعدی نانویی» راهحل درمان رایجترین علت نابینایی

به گزارش گروه وبگردی حیات؛ دانشپژوهان انگلیسی موفق شدند از فناوری نانو برای توسعه داربست سهبعدی استفاده کنند که از رشد سلولهای سالم شبکیه حمایت میکند. این پیشرفت علمی میتواند درمان تباهی لکه زرد (دژنراسیون ماکولا وابسته به سن) (AMD) را که علت اصلی نابینایی در جهان است، متحول کند.
محققان با استفاده از فناوری الکترواسپینینگ (برق ریسی)، داربستی را ایجاد کردند که در صورت آغشته شدن به «آستروئید فلووسینولون استونید»، انعطافپذیری و رشد سلولهای اپیتلیال رنگدانه شبکیه را افزایش میدهد و بهطور بالقوه به توسعه بافت چشم برای پیوند کمک میکند.
باربارا پیرسونک از دانشگاه آنگلیا راسکین (ARU) انگلیس و همکارانش روی روشی برای رشد موفقیتآمیز سلولهای اپیتلیال رنگدانه شبکیه (RPE) کار کردهاند که تا ۱۵۰ روز سالم و زنده میمانند.
سلولهای اپیتلیال رنگدانه شبکیه درست خارج از بخش عصبی شبکیه قرار دارند و در صورت آسیبدیدگی میتوانند باعث کاهش بینایی را در پی داشته باشند.
این نخستین باری است که از فناوری «برق ریسی» برای ایجاد داربستی استفاده میشود که سلولهای اپیتلیال رنگدانه شبکیه روی آن رشد میکنند و میتواند درمان یکی از دژنراسیون ماکولا مرتبط با سن، یکی از شایعترین شکایات بینایی در جهان را متحول کند.
هنگامیکه داربست با استروئیدی به نام فلووسینولون استونید که از التهاب محافظت میکند، آغشته میشود، به نظر میرسد انعطافپذیری سلولها افزایش مییابد و باعث رشد سلولهای چشم میشود. این یافتهها در توسعه آینده بافت چشم برای پیوند به چشم بیمار مهم هستند.
جایگزینی سلولهای اپیتلیال رنگدانه شبکیه یکی از چندین گزینه درمانی امیدوارکننده برای درمان مؤثر بیماریهای بینایی مانند AMD است و محققان روی روشهای کارآمد برای پیوند این سلولها به چشم کار کردهاند.
دژنراسیون ماکولا وابسته به سن (AMD) یکی از علل اصلی نابینایی در کشورهای توسعه یافته است و انتظار میرود در سالهای آینده به دلیل پیری جمعیت افزایش یابد. تحقیقات اخیر پیشبینی کرده است که ۷۷ میلیون نفر فقط در اروپا تا سال ۲۰۵۰ بهنوعی AMD مبتلا خواهند شد.
دژنراسیون ماکولا وابسته به سن میتواند ناشی از تغییرات در غشای بروخ (داخلیترین لایه مشیمیه) باشد که از سلولهای اپیتلیال رنگدانه شبکیه پشتیبانی میکند و همچنین در نتیجه از بین رفتن کوریوکاپیلاریس، بستر عروقی غنی که در مجاورت طرف دیگر غشای بروخ قرار دارد.
در کشورهای غربی، شایعترین علت نابینایی، تجمع رسوبات لیپیدی به نام دروسن و درنتیجه تخریب بخشهایی از سلولهای اپیتلیال رنگدانه شبکیه، کوریوکاپیلاریس و شبکیه بیرونی است.
در کشورهای در حال توسعه، دژنراسیون ماکولا وابسته به سن به دلیل رشد غیرطبیعی عروق خونی در مشیمیه و حرکت متعاقب آن به داخل سلولهای اپیتلیال رنگدانه شبکیه ایجاد شده که منجر به خونریزی، جداشدن RPE یا شبکیه و تشکیل اسکار میشود.
پیرسونیک میگوید: این تحقیق برای اولین بار نشان داد که داربستهای نانوالیافی آغشته به ماده ضدالتهابی مانند فلووسینولون استونید، میتوانند باعث افزایش رشد، تمایز و عملکرد سلولهای RPE شوند.
در گذشته، دانشمندان سلولها را روی یک سطح صاف رشد میدادند که از نظر بیولوژیکی کارآمد نیست. با استفاده از این روشهای جدید نشان داده شده است که خط سلولی در محیط سهبعدی داربستها رشد میکند.
این سیستم پتانسیل زیادی را برای توسعه بهعنوان یک غشای جایگزین بروخ نشان میدهد که یک پشتیبانی مصنوعی، غیر سمی و زیست پایدار برای پیوند سلولهای اپیتلیال رنگدانه شبکیه ارائه میکند. تغییرات پاتولوژیک در این غشاء بهعنوان علت بیماریهای چشمی مانند AMD شناخته شدهاند، و این یک پیشرفت هیجانانگیز است که بهطور بالقوه میتواند به میلیونها نفر در سراسر جهان کمک کند.

نظر شما